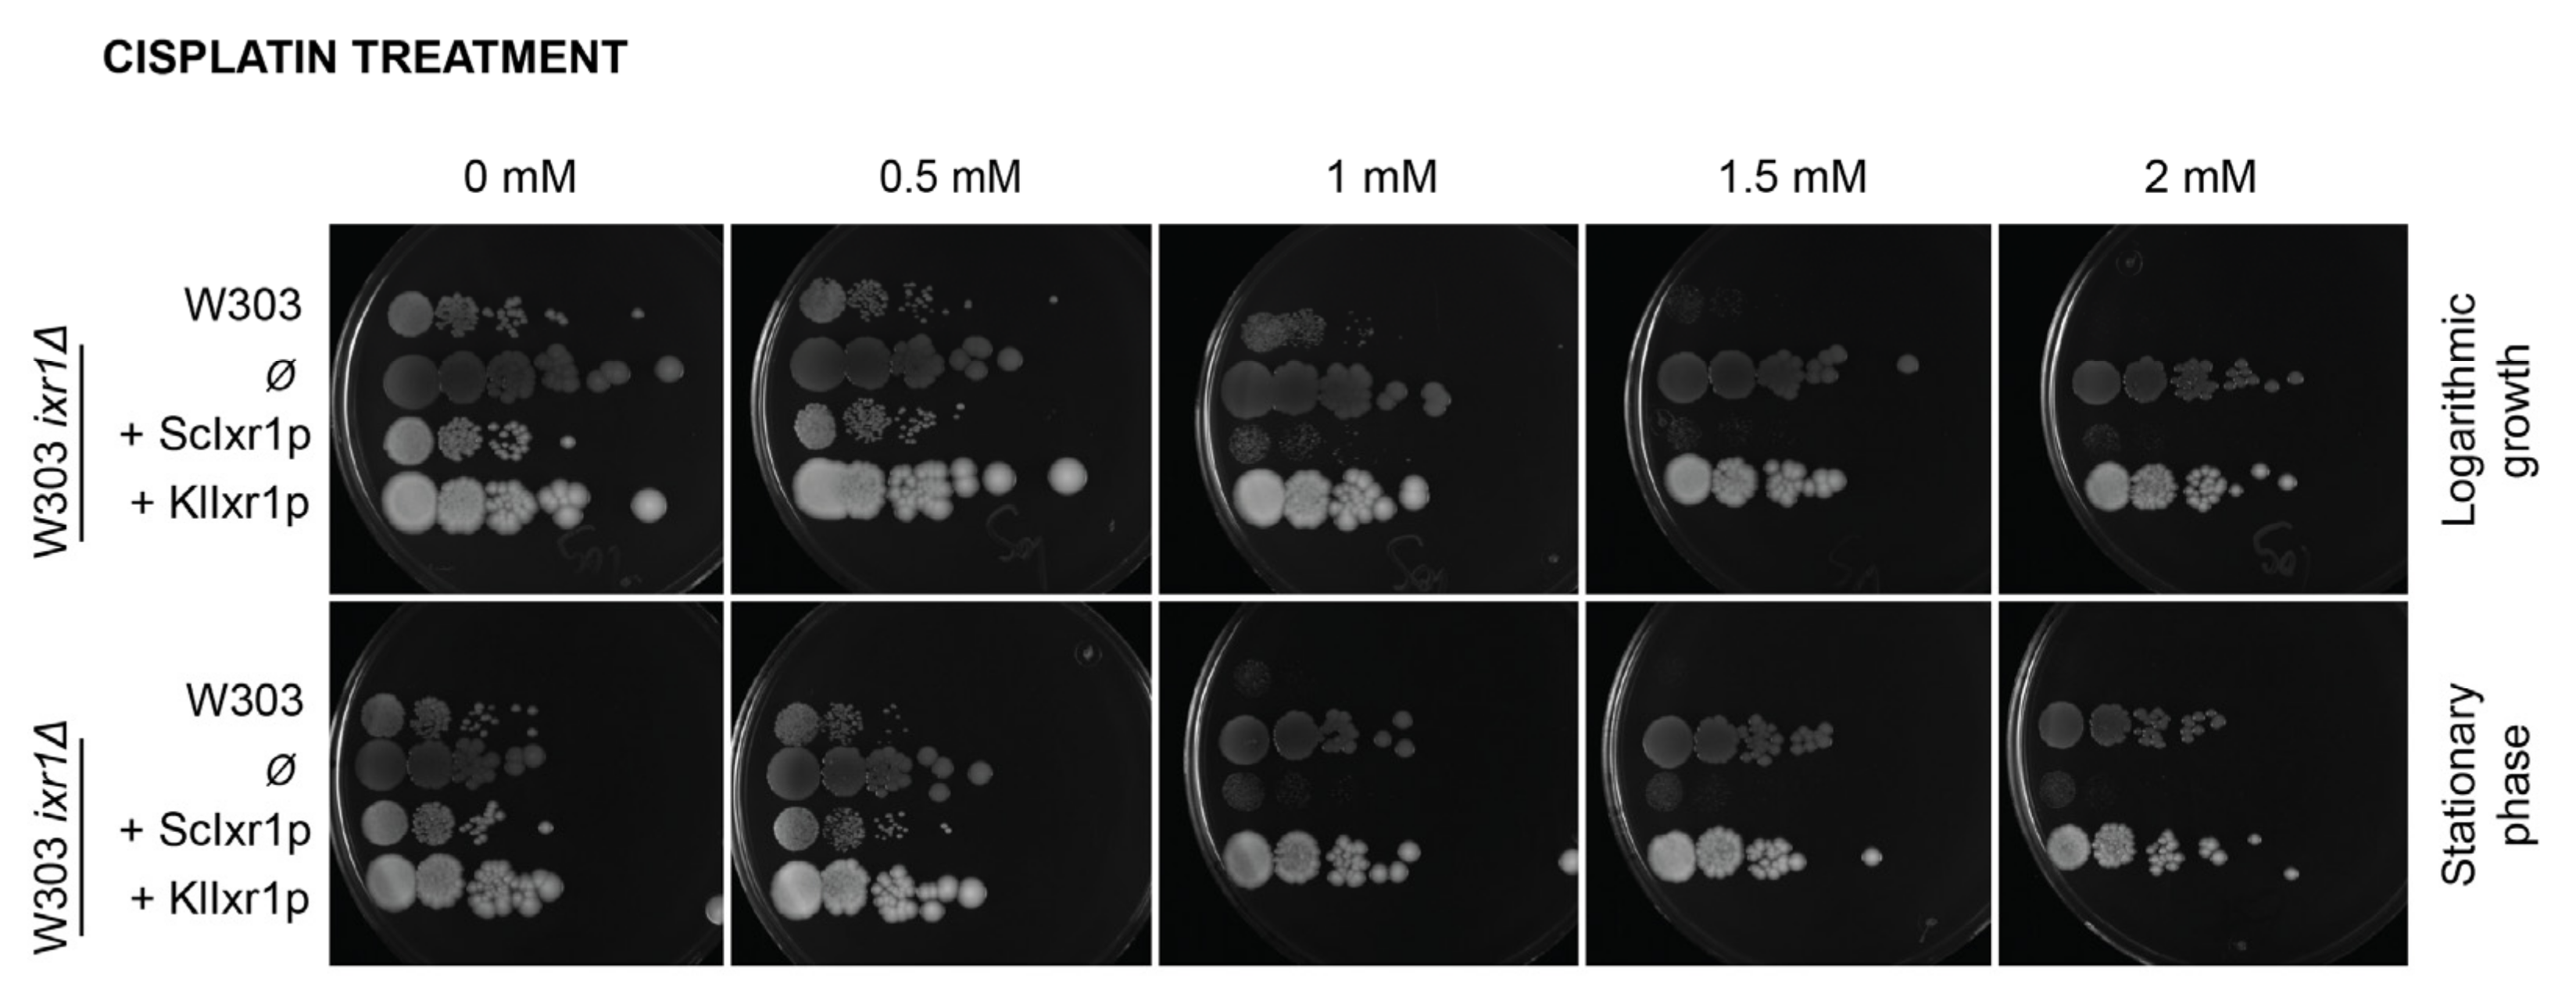
Biomolecules 11 01392 g002 Biomolecules 11 01392 g002

The HMGB Protein KlIxr1, a DNA Binding Regulator of Kluyveromyces lactis Gene Expression Involved in Oxidative Metabolism, Growth, and dNTP Synthesis
Abstract
1. Introduction
2. Materials and Methods
2.1. Yeast Strains, Media, and Growth Condition
2.2. General Techniques
2.3. Construction and Verification of the KlIXR1 Null Strain
2.4. Northern Blotting
2.5. Analysis of Expression by RT-qPCR
2.6. Isolation of KlIxr1 Protein
2.7. Electrophoretic Mobility Shift Assay
2.8. Fluorescence Anisotropy Experiments
2.9. Bioinformatics Analysis and 3-D Modelling
3. Results
3.1. Heterologous Expression of KLLA0E18481g (KlIXR1) in Saccharomyces Cerevisiae Does Not Complement the Increased Resistance to Cisplatin Observed in the S. cerevisiae ixr1Δ Mutant
3.2. KlIXR1 Is Not Related to Cisplatin Sensitivity in K. lactis
3.3. KlIxr1 Controls the Expression of Genes Related to rRNA Processing and Ribosome Biogenesis in K. lactis
3.4. KlIXR1 Regulates the Expression of the KlHEM13 Gene
3.5. KlIxr1 Is Implicated in the Response to Hydrogen Peroxide and Cadmium-Metals
3.6. Deletion of KlIXR1 Causes Petite Colonies That Are Not Related to Carbon Source, Cell Cycle Control, or Defects in Heme Production
3.7. KlIxr1 and the Regulation of Genes Related to De Novo dNTP Synthesis
4. Discussion
5. Conclusions
Supplementary Materials
Author Contributions
Funding
Institutional Review Board Statement
Informed Consent Statement
Data Availability Statement
Conflicts of Interest
References
- Dhakal, S.; Macreadie, I. Protein Homeostasis Networks and the Use of Yeast to Guide Interventions in Alzheimer’s Disease. Int. J. Mol. Sci. 2020, 21, 8014. [Google Scholar] [CrossRef]
- Chernova, T.A.; Chernoff, Y.O.; Wilkinson, K.D. Yeast Models for Amyloids and Prions: Environmental Modulation and Drug Discovery. Molecules 2019, 24, 3388. [Google Scholar] [CrossRef] [PubMed]
- Rzepnikowska, W.; Kaminska, J.; Kabzińska, D.; Binięda, K.; Kochański, A. A Yeast-Based Model for Hereditary Motor and Sensory Neuropathies: A Simple System for Complex, Heterogeneous Diseases. Int. J. Mol. Sci. 2020, 21, 4277. [Google Scholar] [CrossRef] [PubMed]
- Wendland, J. Special Issue: Non-Conventional Yeasts: Genomics and Biotechnology. Microorganisms 2020, 8, 21. [Google Scholar] [CrossRef] [PubMed]
- Rebello, S.; Abraham, A.; Madhavan, A.; Sindhu, R.; Binod, P.; Karthika Bahuleyan, A.; Aneesh, E.M.; Pandey, A. Non-conventional yeast cell factories for sustainable bioprocesses. FEMS Microbiol. Lett. 2018, 365. [Google Scholar] [CrossRef] [PubMed]
- Vizoso-Vázquez, A.; Lamas-Maceiras, M.; Fernández-Leiro, R.; Rico-Díaz, A.; Becerra, M.; Cerdán, M.E. Dual function of Ixr1 in transcriptional regulation and recognition of cisplatin-DNA adducts is caused by differential binding through its two HMG-boxes. Biochim. Biophys. Acta-Gene Regul. Mech. 2017, 1860, 256–269. [Google Scholar] [CrossRef]
- Ye, Y.; Zeng, Z.; Jin, T.; Zhang, H.; Xiong, X.; Gu, L. The Role of High Mobility Group Box 1 in Ischemic Stroke. Front. Cell. Neurosci. 2019, 13, 127. [Google Scholar] [CrossRef]
- Štros, M.; Kučírek, M.; Sani, S.A.; Polanská, E. HMGB1-mediated DNA bending: Distinct roles in increasing p53 binding to DNA and the transactivation of p53-responsive gene promoters. Biochim. Biophys. Acta-Gene Regul. Mech. 2018, 1861, 200–210. [Google Scholar] [CrossRef] [PubMed]
- Tang, D.; Kang, R.; Livesey, K.M.; Cheh, C.-W.; Farkas, A.; Loughran, P.; Hoppe, G.; Bianchi, M.E.; Tracey, K.J.; Zeh III, H.J.; et al. Endogenous HMGB1 regulates autophagy. J. Cell Biol. 2010, 190, 881–892. [Google Scholar] [CrossRef]
- Tang, D.; Kang, R.; Livesey, K.M.; Kroemer, G.; Billiar, T.R.; Van Houten, B.; Zeh III, H.J.; Lotze, M.T. High-Mobility Group Box 1 Is Essential for Mitochondrial Quality Control. Cell Metab. 2011, 13, 701–711. [Google Scholar] [CrossRef]
- Livesey, K.M.; Kang, R.; Zeh Herbert, J., III; Lotze, M.T.; Tang, D. Direct molecular interactions between HMGB1 and TP53 in colorectal cancer. Autophagy 2012, 8, 846–848. [Google Scholar] [CrossRef] [PubMed]
- Andersson, U.; Yang, H.; Harris, H. High-mobility group box 1 protein (HMGB1) operates as an alarmin outside as well as inside cells. Semin. Immunol. 2018, 38, 40–48. [Google Scholar] [CrossRef] [PubMed]
- Niu, L.; Yang, W.; Duan, L.; Wang, X.; Li, Y.; Xu, C.; Liu, C.; Zhang, Y.; Zhou, W.; Liu, J.; et al. Biological functions and theranostic potential of HMGB family members in human cancers. Ther. Adv. Med. Oncol. 2020, 12, 1758835920970850. [Google Scholar] [CrossRef] [PubMed]
- Zhao, Z.; Hu, Z.; Zeng, R.; Yao, Y. HMGB1 in kidney diseases. Life Sci. 2020, 259, 118203. [Google Scholar] [CrossRef]
- Kaur, I.; Behl, T.; Bungau, S.; Kumar, A.; Mehta, V.; Setia, D.; Uddin, M.S.; Zengin, G.; Aleya, L.; Arora, S. Exploring the therapeutic promise of targeting HMGB1 in rheumatoid arthritis. Life Sci. 2020, 258, 118164. [Google Scholar] [CrossRef]
- Paudel, Y.N.; Angelopoulou, E.; Piperi, C.; Othman, I.; Aamir, K.; Shaikh, M.F. Impact of HMGB1, RAGE, and TLR4 in Alzheimer’s Disease (AD): From Risk Factors to Therapeutic Targeting. Cells 2020, 9, 383. [Google Scholar] [CrossRef] [PubMed]
- Vijayakumar, E.C.; Bhatt, L.K.; Prabhavalkar, K.S. High Mobility Group Box-1 (HMGB1): A Potential Target in Therapeutics. Curr. Drug Targets 2019, 20, 1474–1485. [Google Scholar] [CrossRef] [PubMed]
- Flores, C.-L.; Rodríguez, C.; Petit, T.; Gancedo, C. Carbohydrate and energy-yielding metabolism in non-conventional yeasts1. FEMS Microbiol. Rev. 2000, 24, 507–529. [Google Scholar] [CrossRef] [PubMed]
- González-Siso, M.I.; García-Leiro, A.; Tarrío, N.; Cerdán, M.E. Sugar metabolism, redox balance and oxidative stress response in the respiratory yeast Kluyveromyces lactis. Microb. Cell Fact. 2009, 8, 46. [Google Scholar] [CrossRef]
- González–Siso, M.I.; Freire–Picos, M.A.; Ramil, E.; González-Domínguez, M.; Rodríguez Torres, A.; Cerdán, M.E. Respirofermentative metabolism in Kluyveromyces lactis: Insights and perspectives. Enzyme Microb. Technol. 2000, 26, 699–705. [Google Scholar] [CrossRef]
- Lambert, J.R.; Bilanchone, V.W.; Cumsky, M.G. The ORD1 gene encodes a transcription factor involved in oxygen regulation and is identical to IXR1, a gene that confers cisplatin sensitivity to Saccharomyces cerevisiae. Proc. Natl. Acad. Sci. USA 1994, 91, 7345–7349. [Google Scholar] [CrossRef] [PubMed]
- Bourdineaud, J.-P.; De Sampaïo, G.; Lauquin, G.J.-M. A Rox1-independent hypoxic pathway in yeast. Antagonistic action of the repressor Ord1 and activator Yap1 for hypoxic expression of the SRP1/TIR1 gene. Mol. Microbiol. 2000, 38, 879–890. [Google Scholar] [CrossRef]
- Castro-Prego, R.; Lamas-Maceiras, M.; Soengas, P.; Carneiro, I.; González-Siso, I.; Cerdán, M.E. Regulatory factors controlling transcription of Saccharomyces cerevisiae IXR1 by oxygen levels: A model of transcriptional adaptation from aerobiosis to hypoxia implicating ROX1 and IXR1 cross-regulation. Biochem. J. 2009, 425, 235–243. [Google Scholar] [CrossRef]
- Castro-Prego, R.; Lamas-Maceiras, M.; Soengas, P.; Fernández-Leiro, R.; Carneiro, I.; Becerra, M.; González-Siso, M.I.; Cerdán, M.E. Ixr1p regulates oxygen-dependent HEM13 transcription. FEMS Yeast Res. 2010, 10, 309–321. [Google Scholar] [CrossRef] [PubMed]
- Vizoso-Vázquez, Á.; Lamas-Maceiras, M.; Becerra, M.; González-Siso, M.I.; Rodríguez-Belmonte, E.; Cerdán, M.E. Ixr1p and the control of the Saccharomyces cerevisiae hypoxic response. Appl. Microbiol. Biotechnol. 2012, 94, 173–184. [Google Scholar] [CrossRef] [PubMed]
- Klinkenberg, L.G.; Mennella, T.A.; Luetkenhaus, K.; Zitomer, R.S. Combinatorial Repression of the Hypoxic Genes of Saccharomyces cerevisiae by DNA Binding Proteins Rox1 and Mot3. Eukaryot. Cell 2005, 4, 649–660. [Google Scholar] [CrossRef] [PubMed]
- Brown, S.J.; Kellett, P.J.; Lippard, S.J. Ixr1, a yeast protein that binds to platinated DNA and confers sensitivity to cisplatin. Science 1993, 261, 603–605. [Google Scholar] [CrossRef] [PubMed]
- McA’Nulty, M.M.; Lippard, S.J. The HMG-domain protein Ixr1 blocks excision repair of cisplatin-DNA adducts in yeast. Mutat. Res. Repair 1996, 362, 75–86. [Google Scholar] [CrossRef]
- Vizoso-Vázquez, Á.; Lamas-Maceiras, M.; González-Siso, M.I.; Cerdán, M.E. Ixr1 Regulates Ribosomal Gene Transcription and Yeast Response to Cisplatin. Sci. Rep. 2018, 8, 3090. [Google Scholar] [CrossRef]
- Vizoso-Vázquez, A.; Barreiro-Alonso, A.; González-Siso, M.I.; Rodríguez-Belmonte, E.; Lamas-Maceiras, M.; Cerdán, M.E. HMGB proteins involved in TOR signaling as general regulators of cell growth by controlling ribosome biogenesis. Curr. Genet. 2018, 64, 1205–1213. [Google Scholar] [CrossRef]
- Tsaponina, O.; Barsoum, E.; Åström, S.U.; Chabes, A. Ixr1 Is Required for the Expression of the Ribonucleotide Reductase Rnr1 and Maintenance of dNTP Pools. PLoS Genet. 2011, 7, e1002061. [Google Scholar] [CrossRef]
- Ros-Carrero, C.; Ramos-Alonso, L.; Romero, A.M.; Bañó, M.C.; Martínez-Pastor, M.T.; Puig, S. The yeast Aft1 transcription factor activates ribonucleotide reductase catalytic subunit RNR1 in response to iron deficiency. Biochim. Biophys. Acta-Gene Regul. Mech. 2020, 1863, 194522. [Google Scholar] [CrossRef]
- Tsaponina, O.; Chabes, A. Pre-activation of the genome integrity checkpoint increases DNA damage tolerance. Nucleic Acids Res. 2013, 41, 10371–10378. [Google Scholar] [CrossRef]
- Breunig, K.D.; Bolotin-Fukuhara, M.; Bianchi, M.M.; Bourgarel, D.; Falcone, C.; Ferrero, I.; Frontali, L.; Goffrini, P.; Krijger, J.J.; Mazzoni, C.; et al. Regulation of primary carbon metabolism in Kluyveromyces lactis. Enzyme Microb. Technol. 2000, 26, 771–780. [Google Scholar] [CrossRef]
- Rodríguez Torres, A.M.; Lamas Maceiras, M.; Rodríguez Belmonte, E.; Núñez Naveira, L.; Blanco Calvo, M.; Cerdán, M.E. KlRox1p contributes to yeast resistance to metals and is necessary for KlYCF1 expression in the presence of cadmium. Gene 2012, 497, 27–37. [Google Scholar] [CrossRef] [PubMed]
- Fang, Z.-A.; Wang, G.-H.; Chen, A.-L.; Li, Y.-F.; Liu, J.-P.; Li, Y.-Y.; Bolotin-Fukuhara, M.; Bao, W.-G. Gene Responses to Oxygen Availability in Kluyveromyces lactis: An Insight on the Evolution of the Oxygen-Responding System in Yeast. PLoS ONE 2009, 4, e7561. [Google Scholar] [CrossRef] [PubMed]
- Rodríguez Lombardero, S.; Vizoso Vázquez, Á.; Rodríguez Belmonte, E.; González Siso, M.I.; Cerdán, M.E. SKY1 and IXR1 interactions, their effects on cisplatin and spermine resistance in Saccharomyces cerevisiae. Can. J. Microbiol. 2012, 58, 184–188. [Google Scholar] [CrossRef] [PubMed]
- Zitomer, R.S.; Hall, B.D. Yeast cytochrome c messenger RNA. In vitro translation and specific immunoprecipitation of the CYC1 gene product. J. Biol. Chem. 1976, 251, 6320–6326. [Google Scholar] [CrossRef]
- Ito, H.; Fukuda, Y.; Murata, K.; Kimura, A. Transformation of intact yeast cells treated with alkali cations. J. Bacteriol. 1983, 153, 163–168. [Google Scholar] [CrossRef] [PubMed]
- Gietz, R.D.; Akio, S. New yeast-Escherichia coli shuttle vectors constructed with in vitro mutagenized yeast genes lacking six-base pair restriction sites. Gene 1988, 74, 527–534. [Google Scholar] [CrossRef]
- Wach, A.; Brachat, A.; Pöhlmann, R.; Philippsen, P. New heterologous modules for classical or PCR-based gene disruptions in Saccharomyces cerevisiae. Yeast 1994, 10, 1793–1808. [Google Scholar] [CrossRef]
- Tizón, B.; Rodríguez-Torres, A.M.; Cerdán, M.E. Disruption of six novel Saccharomyces cerevisiae genes reveals that YGL129c is necessary for growth in non-fermentable carbon sources, YGL128c for growth at low or high temperatures and YGL125w is implicated in the biosynthesis of methionine. Yeast 1999, 15, 145–154. [Google Scholar] [CrossRef]
- Rodríguez-Lombardero, S.; Vizoso-Vázquez, Á.; Lombardía, L.J.; Becerra, M.; González-Siso, M.I.; Cerdán, M.E. Sky1 regulates the expression of sulfur metabolism genes in response to cisplatin. Microbiology 2014, 160, 1357–1368. [Google Scholar] [CrossRef]
- Livak, K.J.; Schmittgen, T.D. Analysis of Relative Gene Expression Data Using Real-Time Quantitative PCR and the 2−ΔΔCT Method. Methods 2001, 25, 402–408. [Google Scholar] [CrossRef] [PubMed]
- Kelley, L.A.; Mezulis, S.; Yates, C.M.; Wass, M.N.; Sternberg, M.J.E. The Phyre2 web portal for protein modeling, prediction and analysis. Nat. Protoc. 2015, 10, 845–858. [Google Scholar] [CrossRef]
- Zhang, Y.; Skolnick, J. TM-align: A protein structure alignment algorithm based on the TM-score. Nucleic Acids Res. 2005, 33, 2302–2309. [Google Scholar] [CrossRef]
- Albert, B.; Tomassetti, S.; Gloor, Y.; Dilg, D.; Mattarocci, S.; Kubik, S.; Hafner, L.; Shore, D. Sfp1 regulates transcriptional networks driving cell growth and division through multiple promoter-binding modes. Genes Dev. 2019, 33, 288–293. [Google Scholar] [CrossRef] [PubMed]
- Martin, D.E.; Soulard, A.; Hall, M.N. TOR Regulates Ribosomal Protein Gene Expression via PKA and the Forkhead Transcription Factor FHL1. Cell 2004, 119, 969–979. [Google Scholar] [CrossRef] [PubMed]
- Fermi, B.; Bosio, M.C.; Dieci, G. Promoter architecture and transcriptional regulation of Abf1-dependent ribosomal protein genes in Saccharomyces cerevisiae. Nucleic Acids Res. 2016, 44, 6113–6126. [Google Scholar] [CrossRef][Green Version]
- Urban, J.; Soulard, A.; Huber, A.; Lippman, S.; Mukhopadhyay, D.; Deloche, O.; Wanke, V.; Anrather, D.; Ammerer, G.; Riezman, H.; et al. Sch9 Is a Major Target of TORC1 in Saccharomyces cerevisiae. Mol. Cell 2007, 26, 663–674. [Google Scholar] [CrossRef] [PubMed]
- Dirmeier, R.; O’Brien, K.M.; Engle, M.; Dodd, A.; Spears, E.; Poyton, R.O. Exposure of yeast cells to anoxia induces transient oxidative stress. Implications for the induction of hypoxic genes. J. Biol. Chem. 2002, 277, 34773–34784. [Google Scholar] [CrossRef] [PubMed]
- Hosiner, D.; Gerber, S.; Lichtenberg-Fraté, H.; Glaser, W.; Schüller, C.; Klipp, E. Impact of Acute Metal Stress in Saccharomyces cerevisiae. PLoS ONE 2014, 9, e83330. [Google Scholar] [CrossRef]
- Li, Z.-S.; Lu, Y.-P.; Zhen, R.-G.; Szczypka, M.; Thiele, D.J.; Rea, P.A. A New Pathway for Vacuolar Cadmium Sequestration in Saccharomyces cerevisiae: YCF1-Catalyzed Transport of bis(glutathionato)cadmium. Proc. Natl. Acad. Sci. USA 1997, 94, 42–47. [Google Scholar] [CrossRef] [PubMed]
- Tommasini, R.; Evers, R.; Vogt, E.; Mornet, C.; Zaman, G.J.; Schinkel, A.H.; Borst, P.; Martinoia, E. The human multidrug resistance-associated protein functionally complements the yeast cadmium resistance factor 1. Proc. Natl. Acad. Sci. USA 1996, 93, 6743–6748. [Google Scholar] [CrossRef]
- Wei, W.; Smith, N.; Wu, X.; Kim, H.; Seravalli, J.; Khalimonchuk, O.; Lee, J. YCF1-Mediated Cadmium Resistance in Yeast Is Dependent on Copper Metabolism and Antioxidant Enzymes. Antioxid. Redox Signal. 2014, 21, 1475–1489. [Google Scholar] [CrossRef] [PubMed]
- Brückner, S.; Kern, S.; Birke, R.; Saugar, I.; Ulrich, H.D.; Mösch, H.-U. The TEA Transcription Factor Tec1 Links TOR and MAPK Pathways to Coordinate Yeast Development. Genetics 2011, 189, 479–494. [Google Scholar] [CrossRef][Green Version]
- Galit, S.; Yona, K. A Positive Regulator of Mitosis, Sok2, Functions as a Negative Regulator of Meiosis in Saccharomyces cerevisiae. Mol. Cell. Biol. 2001, 21, 1603–1612. [Google Scholar] [CrossRef]
- Hanlon, S.E.; Rizzo, J.M.; Tatomer, D.C.; Lieb, J.D.; Buck, M.J. The Stress Response Factors Yap6, Cin5, Phd1, and Skn7 Direct Targeting of the Conserved Co-Repressor Tup1-Ssn6 in S. cerevisiae. PLoS ONE 2011, 6, e19060. [Google Scholar] [CrossRef]
- Tam, J.; van Werven, F.J. Regulated repression governs the cell fate promoter controlling yeast meiosis. Nat. Commun. 2020, 11, 2271. [Google Scholar] [CrossRef] [PubMed]
- Desany, B.A.; Alcasabas, A.A.; Bachant, J.B.; Elledge, S.J. Recovery from DNA replicational stress is the essential function of the S-phase checkpoint pathway. Genes Dev. 1998, 12, 2956–2970. [Google Scholar] [CrossRef]
- Zaim, J.; Speina, E.; Kierzek, A.M. Identification of New Genes Regulated by the Crt1 Transcription Factor, an Effector of the DNA Damage Checkpoint Pathway in Saccharomyces cerevisiae. J. Biol. Chem. 2005, 280, 28–37. [Google Scholar] [CrossRef]
- Huang, M.; Zhou, Z.; Elledge, S.J. The DNA replication and damage checkpoint pathways induce transcription by inhibition of the Crt1 repressor. Cell 1998, 94, 595–605. [Google Scholar] [CrossRef]
- Klinkenberg, L.G.; Webb, T.; Zitomer, R.S. Synergy among differentially regulated repressors of the ribonucleotide diphosphate reductase genes of Saccharomyces cerevisiae. Eukaryot. Cell 2006, 5, 1007–1017. [Google Scholar] [CrossRef]
- Fu, Y.; Xiao, W. Identification and characterization of CRT10 as a novel regulator of Saccharomyces cerevisiae ribonucleotide reductase genes. Nucleic Acids Res. 2006, 34, 1876–1883. [Google Scholar] [CrossRef]
- Lepperdinger, G.; Berger, P.; Breitenbach, M.; Frohlich, K.U.; Grillari, J.; Grubeck-Loebenstein, B.; Madeo, F.; Minois, N.; Zwerschke, W.; Jansen-Durr, P. The use of genetically engineered model systems for research on human aging. Front. Biosci. 2008, 13, 7022–7031. [Google Scholar] [CrossRef] [PubMed][Green Version]
- Petranovic, D.; Nielsen, J. Can yeast systems biology contribute to the understanding of human disease? Trends Biotechnol. 2008, 26, 584–590. [Google Scholar] [CrossRef] [PubMed]
- González Siso, M.I.; Cerdán, M.E. Kluyveromyces lactis: A Suitable Yeast Model to Study Cellular Defense Mechanisms against Hypoxia-Induced Oxidative Stress. Oxid. Med. Cell. Longev. 2012, 2012, 634674. [Google Scholar] [CrossRef] [PubMed]
- Wolfe, K.H. Origin of the Yeast Whole-Genome Duplication. PLoS Biol. 2015, 13, 1–7. [Google Scholar] [CrossRef] [PubMed]
- Shertz, C.A.; Bastidas, R.J.; Li, W.; Heitman, J.; Cardenas, M.E. Conservation, duplication, and loss of the Tor signaling pathway in the fungal kingdom. BMC Genom. 2010, 11, 510. [Google Scholar] [CrossRef] [PubMed]
- Núñez, L.; Rodríguez-Torres, A.; Cerdán, M.E. Regulatory elements in the KlHEM1 promoter. Biochim. Biophys. Acta-Gene Regul. Mech. 2008, 1779, 128–133. [Google Scholar] [CrossRef] [PubMed]
- González-Domínguez, M.; Méndez-Carro, C.; Esperanza Cerdán, M. Isolation and Characterization of the KlHEM1 Gene in Kluyveromyces lactis. Yeast 1997, 13, 961–971. [Google Scholar] [CrossRef]
- Blanco, M.; Becerra, M.; González-Siso, M.I.; Cerdán, M.E. Functional characterization of KlHEM13, a hypoxic gene of Kluyveromyces lactis. Can. J. Microbiol. 2005, 51, 241–249. [Google Scholar] [CrossRef] [PubMed]
- Lamas-Maceiras, M.; Núñez, L.; Rodríguez-Belmonte, E.; González-Siso, M.I.; Cerdán, M.E. Functional characterization of KlHAP1: A model to foresee different mechanisms of transcriptional regulation by Hap1p in yeasts. Gene 2007, 405, 96–107. [Google Scholar] [CrossRef] [PubMed]
- Becerra, M.; Lombardía-Ferreira, L.J.; Hauser, N.C.; Hoheisel, J.D.; Tizon, B.; Cerdán, M.E. The yeast transcriptome in aerobic and hypoxic conditions: Effects of hap1, rox1, rox3 and srb10 deletions. Mol. Microbiol. 2002, 43, 545–555. [Google Scholar] [CrossRef]
- Leiro, A.; Rodríguez-Lombardero, S.; Vizoso-Vázquez, A.; González Siso, M.I.; Cerdán, M.E. The Yeast Genes ROX1, IXR1, SKY1 and Their Effect upon Enzymatic Activities Related to Oxidative Stress. Intech 2012, 16, 297–322. [Google Scholar] [CrossRef]
- Loewith, R.; Jacinto, E.; Wullschleger, S.; Lorberg, A.; Crespo, J.L.; Bonenfant, D.; Oppliger, W.; Jenoe, P.; Hall, M.N. Two TOR Complexes, Only One of which Is Rapamycin Sensitive, Have Distinct Roles in Cell Growth Control. Mol. Cell 2002, 10, 457–468. [Google Scholar] [CrossRef]
- Tsang, C.K.; Qi, H.; Liu, L.F.; Zheng, X.F.S. Targeting mammalian target of rapamycin (mTOR) for health and diseases. Drug Discov. Today 2007, 12, 112–124. [Google Scholar] [CrossRef] [PubMed]
- Barbet, N.C.; Schneider, U.; Helliwell, S.B.; Stansfield, I.; Tuite, M.F.; Hall, M.N. TOR controls translation initiation and early G1 progression in yeast. Mol. Biol. Cell 1996, 7, 25–42. [Google Scholar] [CrossRef]

Publisher’s Note: MDPI stays neutral with regard to jurisdictional claims in published maps and institutional affiliations. |
© 2021 by the authors. Licensee MDPI, Basel, Switzerland. This article is an open access article distributed under the terms and conditions of the Creative Commons Attribution (CC BY) license (https://creativecommons.org/licenses/by/4.0/).
Share and Cite
Rico-Díaz, A.; Barreiro-Alonso, A.; Rey-Souto, C.; Becerra, M.; Lamas-Maceiras, M.; Cerdán, M.E.; Vizoso-Vázquez, Á. The HMGB Protein KlIxr1, a DNA Binding Regulator of Kluyveromyces lactis Gene Expression Involved in Oxidative Metabolism, Growth, and dNTP Synthesis. Biomolecules 2021, 11, 1392. https://doi.org/10.3390/biom11091392
Rico-Díaz A, Barreiro-Alonso A, Rey-Souto C, Becerra M, Lamas-Maceiras M, Cerdán ME, Vizoso-Vázquez Á. The HMGB Protein KlIxr1, a DNA Binding Regulator of Kluyveromyces lactis Gene Expression Involved in Oxidative Metabolism, Growth, and dNTP Synthesis. Biomolecules. 2021; 11(9):1392. https://doi.org/10.3390/biom11091392
Chicago/Turabian StyleRico-Díaz, Agustín, Aída Barreiro-Alonso, Cora Rey-Souto, Manuel Becerra, Mónica Lamas-Maceiras, M. Esperanza Cerdán, and Ángel Vizoso-Vázquez. 2021. "The HMGB Protein KlIxr1, a DNA Binding Regulator of Kluyveromyces lactis Gene Expression Involved in Oxidative Metabolism, Growth, and dNTP Synthesis" Biomolecules 11, no. 9: 1392. https://doi.org/10.3390/biom11091392
APA StyleRico-Díaz, A., Barreiro-Alonso, A., Rey-Souto, C., Becerra, M., Lamas-Maceiras, M., Cerdán, M. E., & Vizoso-Vázquez, Á. (2021). The HMGB Protein KlIxr1, a DNA Binding Regulator of Kluyveromyces lactis Gene Expression Involved in Oxidative Metabolism, Growth, and dNTP Synthesis. Biomolecules, 11(9), 1392. https://doi.org/10.3390/biom11091392







